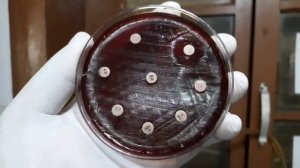
Klebsiella/Staphylococcus/ Beta-haemolytic Streptococci/ Enterococcus/ Serratia/ Micrococcus

1:11:07
1:11:07
2025-02-11 15:47

 6:23
6:23

 6:23
6:23
2024-01-01 12:01

 22:11
22:11

 22:11
22:11
2025-09-25 14:00

 1:55
1:55

 1:55
1:55
2025-02-27 06:37

 0:25
0:25

 0:25
0:25
2024-09-30 13:35

 0:22
0:22

 0:22
0:22
2023-12-20 01:06

 2:14
2:14

 2:14
2:14
2024-11-08 08:19

 0:36
0:36

 0:36
0:36
2024-04-09 06:56

 9:49
9:49
9:49
9:49
2024-04-20 05:22

 0:35
0:35

 0:35
0:35
2025-02-16 03:27

 5:09
5:09

 5:09
5:09
2024-08-04 15:33

 1:04
1:04

 1:04
1:04
2023-09-14 21:22

 2:54
2:54

 2:54
2:54
2023-08-09 10:00

 0:39
0:39

 0:39
0:39
2022-11-17 18:57

 4:51
4:51

 4:51
4:51
2023-08-14 13:51

 2:22
2:22

 2:22
2:22
2023-08-16 11:51

 15:19
15:19

 15:19
15:19
2022-03-14 12:32

 14:47
14:47
![Alex Lim, Игорь Крутой - Вокзал (Премьера клипа 2025)]() 3:32
3:32
![Зафар Эргашов & Фируз Рузметов - Лабларидан (Премьера клипа 2025)]() 4:13
4:13
![NIKA DUBIK, Winter Spirit - Искры (Премьера клипа 2025)]() 4:27
4:27
![Хабибулло Хамроз - Хуп деб куёринг (Премьера клипа 2025)]() 4:04
4:04
![Руслан Шанов - Особенная (Премьера клипа 2025)]() 2:16
2:16
![Алим Аталиков - Как царица (Премьера клипа 2025)]() 3:25
3:25
![Шерзодбек Жонибеков - Дадажон (Премьера клипа 2025)]() 3:02
3:02
![Артур Халатов - Девочка моя (Премьера клипа 2025)]() 2:37
2:37
![Selena Gomez - In The Dark (Official Video 2025)]() 3:04
3:04
![Любовь Попова - Прощай (Премьера клипа 2025)]() 3:44
3:44
![Азимжон Сайфуллаев - Тупрок буламиз (Премьера клипа 2025)]() 4:38
4:38
![Инна Вальтер - Роза (Премьера клипа 2025)]() 3:18
3:18
![Надежда Мельянцева - Котёнок, не плачь (Премьера клипа 2025)]() 3:02
3:02
![Алмас Багратиони - Сила веры (Премьера клипа 2025)]() 3:18
3:18
![Рейсан Магомедкеримов, Ренат Омаров - Бла-та-та (Премьера клипа 2025)]() 2:26
2:26
![Gulinur - Nishatar (Official Video 2025)]() 3:40
3:40
![5sta Family - Антидот (Премьера клипа 2025)]() 3:33
3:33
![Зара - Танго о двух влюбленных кораблях (Премьера клипа 2025)]() 3:10
3:10
![Зара - Прерванный полет (Премьера клипа 2025)]() 5:08
5:08
![Сардор Расулов - Етолмадим (Премьера клипа 2025)]() 4:15
4:15
![Тот самый | Him (2025)]() 1:36:20
1:36:20
![Сумерки | Twilight (2008)]() 2:01:55
2:01:55
![Девушка из каюты №10 | The Woman in Cabin 10 (2025)]() 1:35:11
1:35:11
![Дом из динамита | A House of Dynamite (2025)]() 1:55:08
1:55:08
![Диспетчер | Relay (2025)]() 1:51:56
1:51:56
![Мальчишник в Таиланде | Changeland (2019)]() 1:25:47
1:25:47
![Сколько стоит жизнь? | What Is Life Worth (2020)]() 1:58:51
1:58:51
![Псы войны | Hounds of War (2024)]() 1:34:38
1:34:38
![Хани, не надо! | Honey Don't! (2025)]() 1:29:32
1:29:32
![Вечеринка только начинается | The Party's Just Beginning (2018)]() 1:31:20
1:31:20
![Богомол | Samagwi (2025)]() 1:53:29
1:53:29
![Эффект бабочки | The Butterfly Effect (2003)]() 1:53:35
1:53:35
![Никто 2 | Nobody 2 (2025)]() 1:29:27
1:29:27
![Большое смелое красивое путешествие | A Big Bold Beautiful Journey (2025)]() 1:49:20
1:49:20
![Плюшевый пузырь | The Beanie Bubble (2023)]() 1:50:15
1:50:15
![Мужчина у меня в подвале | The Man in My Basement (2025)]() 1:54:48
1:54:48
![Школьный автобус | The Lost Bus (2025)]() 2:09:55
2:09:55
![Когда ты закончишь спасать мир | When You Finish Saving the World (2022)]() 1:27:40
1:27:40
![Храброе сердце | Braveheart (1995)]() 2:57:46
2:57:46
![Стив | Steve (2025)]() 1:33:34
1:33:34
![Чемпионы]() 7:21
7:21
![Тайны Медовой долины]() 7:01
7:01
![Умка]() 7:11
7:11
![Игрушечный полицейский Сезон 1]() 7:19
7:19
![Сборники «Ну, погоди!»]() 1:10:01
1:10:01
![МиниФорс Сезон 1]() 13:12
13:12
![Приключения Пети и Волка]() 11:00
11:00
![Отряд А. Игрушки-спасатели]() 13:06
13:06
![Пластилинки]() 25:31
25:31
![Новогодние мультики – Союзмультфильм]() 7:04
7:04
![Карли – искательница приключений. Древнее королевство]() 13:00
13:00
![Пип и Альба. Приключения в Соленой Бухте! Сезон 1]() 11:02
11:02
![Команда Дино Сезон 2]() 12:31
12:31
![Команда Дино. Исследователи Сезон 2]() 13:26
13:26
![Сборники «Приключения Пети и Волка»]() 1:50:38
1:50:38
![Монсики]() 6:30
6:30
![Минифорс. Сила динозавров]() 12:51
12:51
![Команда Дино Сезон 1]() 12:08
12:08
![Сборники «Умка»]() 1:20:52
1:20:52
![Истории Баданаму Сезон 1]() 10:02
10:02

 14:47
14:47Скачать видео
| 426x240 | ||
| 640x360 | ||
| 854x480 | ||
| 1280x720 | ||
| 1920x1080 |
 3:32
3:32
2025-10-31 15:50
 4:13
4:13
2025-10-29 10:10
 4:27
4:27
2025-10-31 16:00
 4:04
4:04
2025-10-28 13:40
 2:16
2:16
2025-10-31 12:47
 3:25
3:25
2025-10-29 10:18
 3:02
3:02
2025-10-25 13:03
 2:37
2:37
2025-10-28 10:22
 3:04
3:04
2025-10-24 11:30
 3:44
3:44
2025-10-21 09:25
 4:38
4:38
2025-10-23 11:27
 3:18
3:18
2025-10-28 10:36
 3:02
3:02
2025-10-31 12:43
 3:18
3:18
2025-10-24 12:09
 2:26
2:26
2025-10-22 14:10
 3:40
3:40
2025-10-31 13:38
 3:33
3:33
2025-10-22 13:57
 3:10
3:10
2025-10-27 10:52
 5:08
5:08
2025-10-31 12:50
 4:15
4:15
2025-10-26 12:52
0/0
 1:36:20
1:36:20
2025-10-09 20:02
 2:01:55
2:01:55
2025-08-28 15:32
 1:35:11
1:35:11
2025-10-13 12:06
 1:55:08
1:55:08
2025-10-29 16:30
 1:51:56
1:51:56
2025-09-24 11:35
 1:25:47
1:25:47
2025-08-27 17:17
 1:58:51
1:58:51
2025-08-27 17:17
 1:34:38
1:34:38
2025-08-28 15:32
 1:29:32
1:29:32
2025-09-15 11:39
 1:31:20
1:31:20
2025-08-27 17:17
 1:53:29
1:53:29
2025-10-01 12:06
 1:53:35
1:53:35
2025-09-11 08:20
 1:29:27
1:29:27
2025-09-07 22:44
 1:49:20
1:49:20
2025-10-21 22:50
 1:50:15
1:50:15
2025-08-27 18:32
 1:54:48
1:54:48
2025-10-01 15:17
 2:09:55
2:09:55
2025-10-05 00:32
 1:27:40
1:27:40
2025-08-27 17:17
 2:57:46
2:57:46
2025-08-31 01:03
 1:33:34
1:33:34
2025-10-08 12:27
0/0
 7:21
7:21
2025-10-07 09:00
 7:01
7:01
2022-03-30 17:25
 7:11
7:11
2025-01-13 11:05
2021-09-22 21:03
 1:10:01
1:10:01
2025-07-25 20:16
2021-09-23 00:15
 11:00
11:00
2022-04-01 17:59
 13:06
13:06
2024-11-28 16:30
 25:31
25:31
2022-04-01 14:30
 7:04
7:04
2023-07-25 00:09
 13:00
13:00
2024-11-28 16:19
2021-09-22 23:36
2021-09-22 22:40
2021-09-22 22:54
 1:50:38
1:50:38
2025-10-29 16:37
 6:30
6:30
2022-03-29 19:16
 12:51
12:51
2024-11-27 16:39
2021-09-22 22:29
 1:20:52
1:20:52
2025-09-19 17:54
2021-09-22 21:29
0/0

